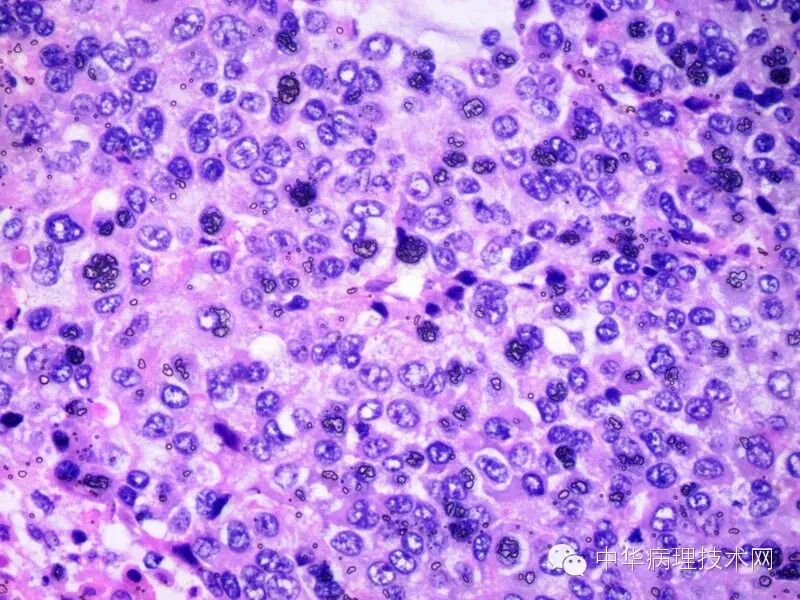

有些单位的切片中经常会看到这些黑色的颗粒,曾经有进修生告诉我:人体中所有的组织内都有黑色素,吓了我一身冷汗,问其原因,原来某大学医学院出的一本组胚图谱里每张照片都有这种黑色的颗粒。
一、这些颗粒是什么?
一、这些颗粒是什么?
其实就是切片经二甲苯透明后,在封片前切片干燥过了,树胶把空气封在切片上产生的不透明折光小泡,通常叫空气结晶。
二、产生原因和解决方法:
1、空气干燥、室内温度高:切片从二甲苯拿出来到封片时挥发引起的快速干燥,常见于手工染色一次性拿出待封切片过多或机器封片时,没有将待封切片放于二甲苯内或封片速度不够快。
解决方法:(1)少拿几张出来待封。(2)机器封片将待封切片放入二甲苯内。(3)如果机器封片速度不够快,可以每架切片少放几张。
2、二甲苯透明后用电吹风吹干、或温箱烤干、或自然干燥。
解决方法:封片前不能采用这些方法,更不能让切片干燥。
三、产生了黑色结晶怎么办?
把切片盖玻片除去,用二甲苯把树胶洗干净,然后用无水酒精把二甲苯洗干净,再回到二甲苯内透明,封片,这些结晶就没有了。当然也有意外的,当细胞涂片产生这种黑色结晶后,不管你怎么搞,这些结晶都可能始终存在,没有办法除去,所以细胞涂片封片时更要注意。
虽然,不经二甲苯透明的切片干燥后封片可能不会出现这种黑色的结晶,但会影响其透明度和色彩鲜艳度,特别是高倍镜下。 一张优秀的切片,应该采用湿封的方法,才能保证其透明度达到最佳的水平。
详见《简明病理学技术》:
 欢迎光临中华病理技术网公众平台(zhbljsw),我们将竭诚为广大病理工作者服务。
欢迎光临中华病理技术网公众平台(zhbljsw),我们将竭诚为广大病理工作者服务。